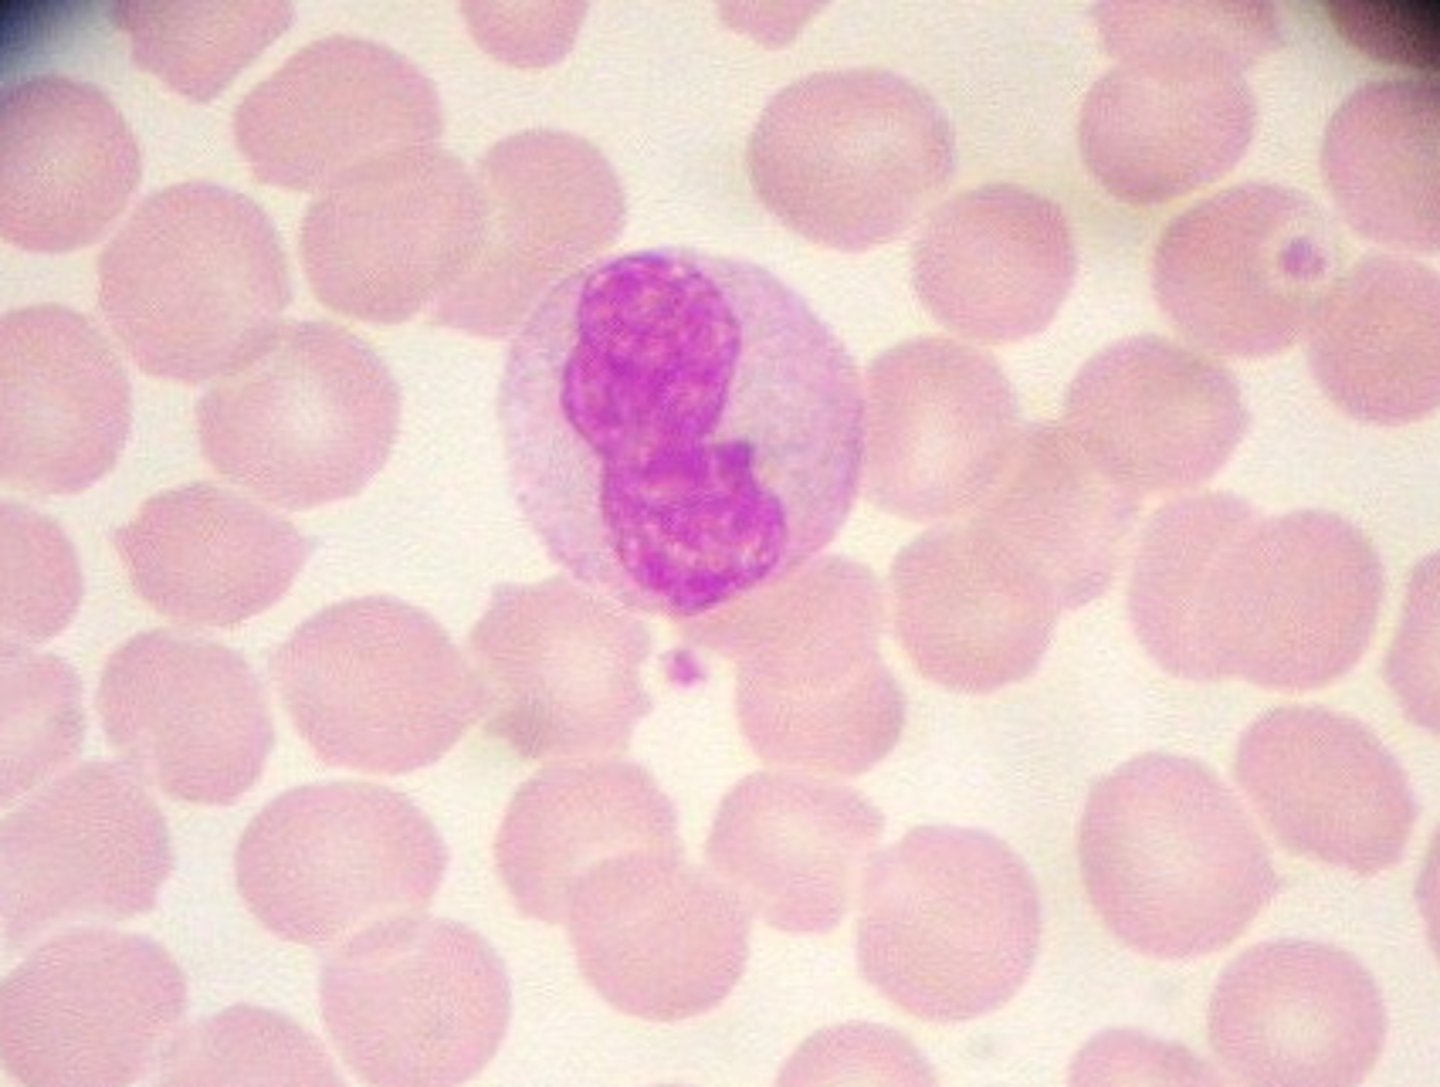
knowt flashcard image
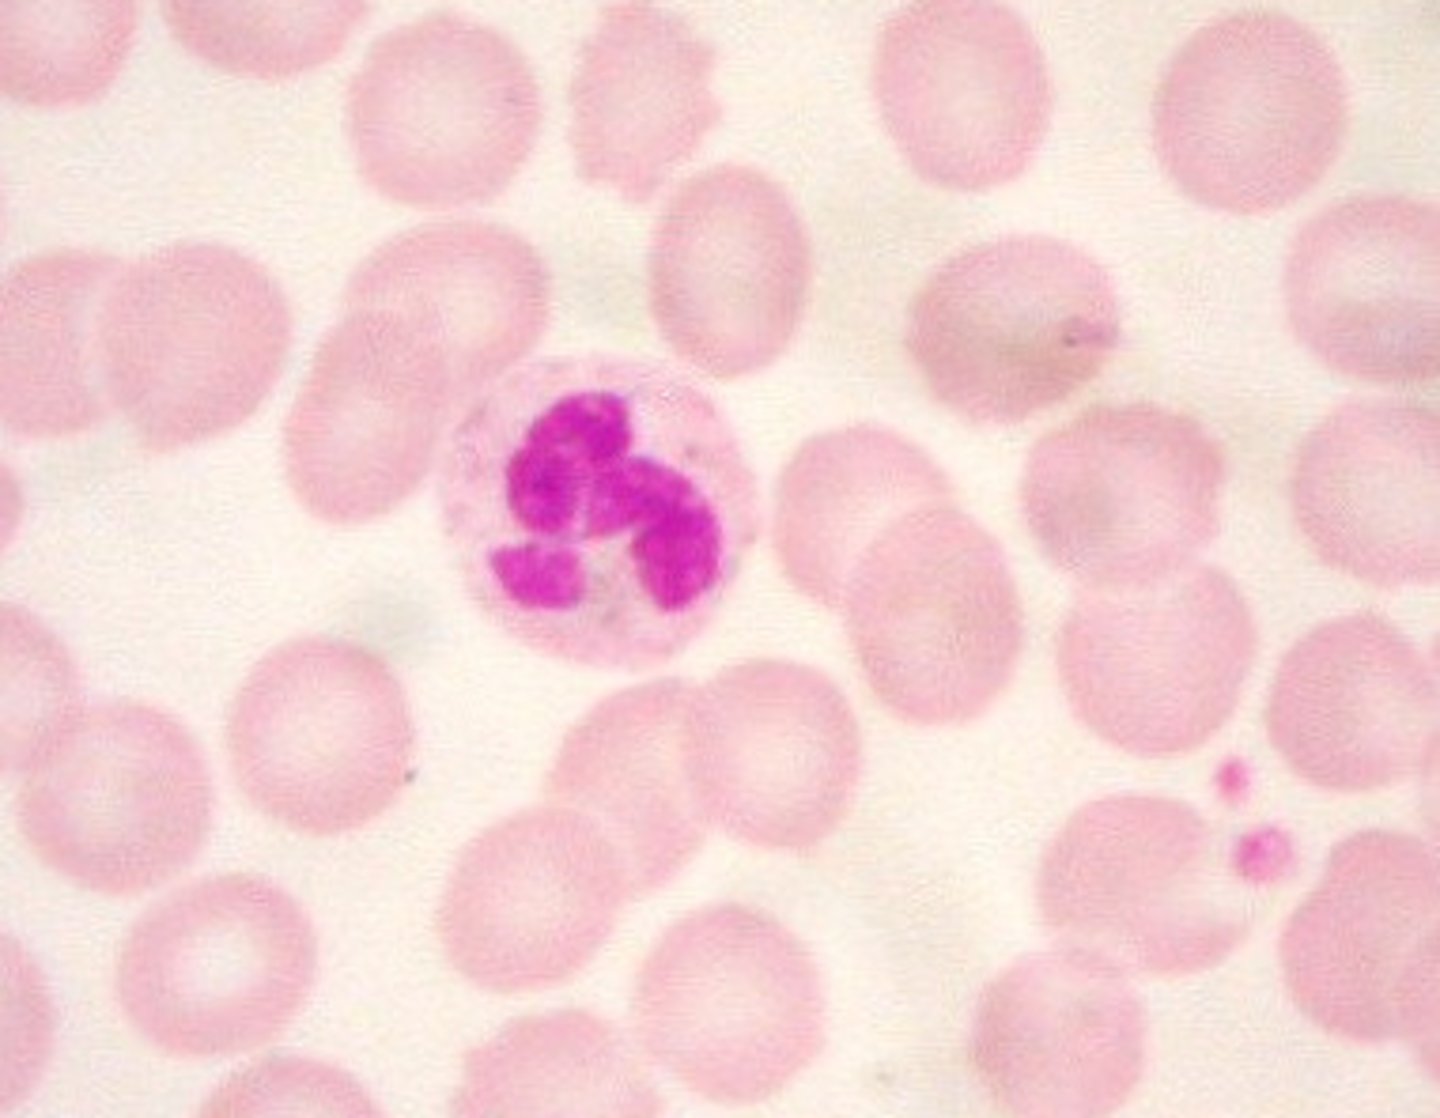
knowt flashcard image
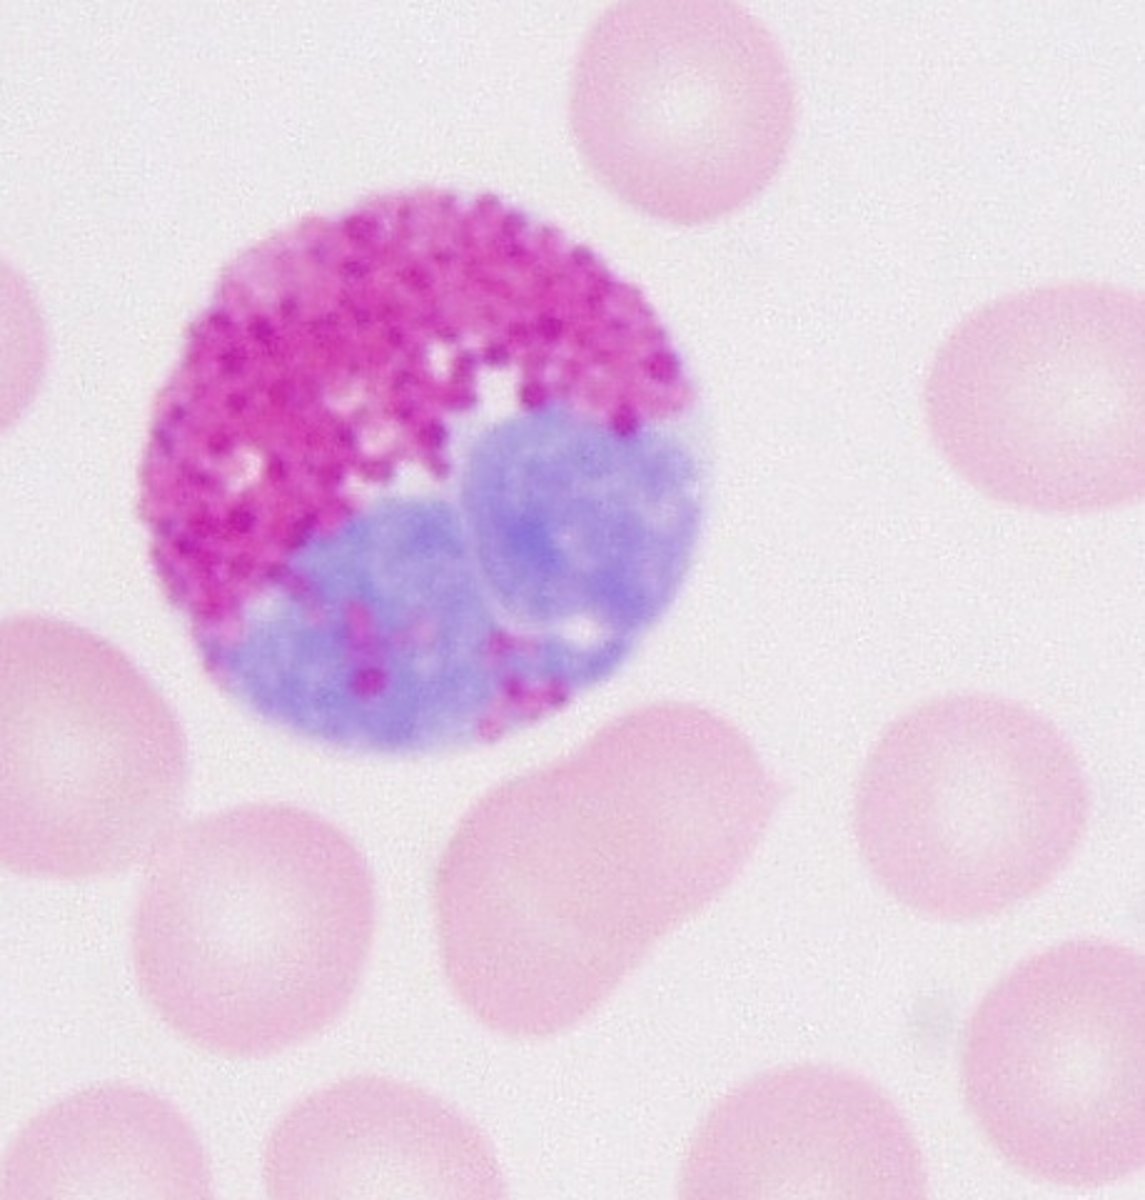
knowt flashcard image
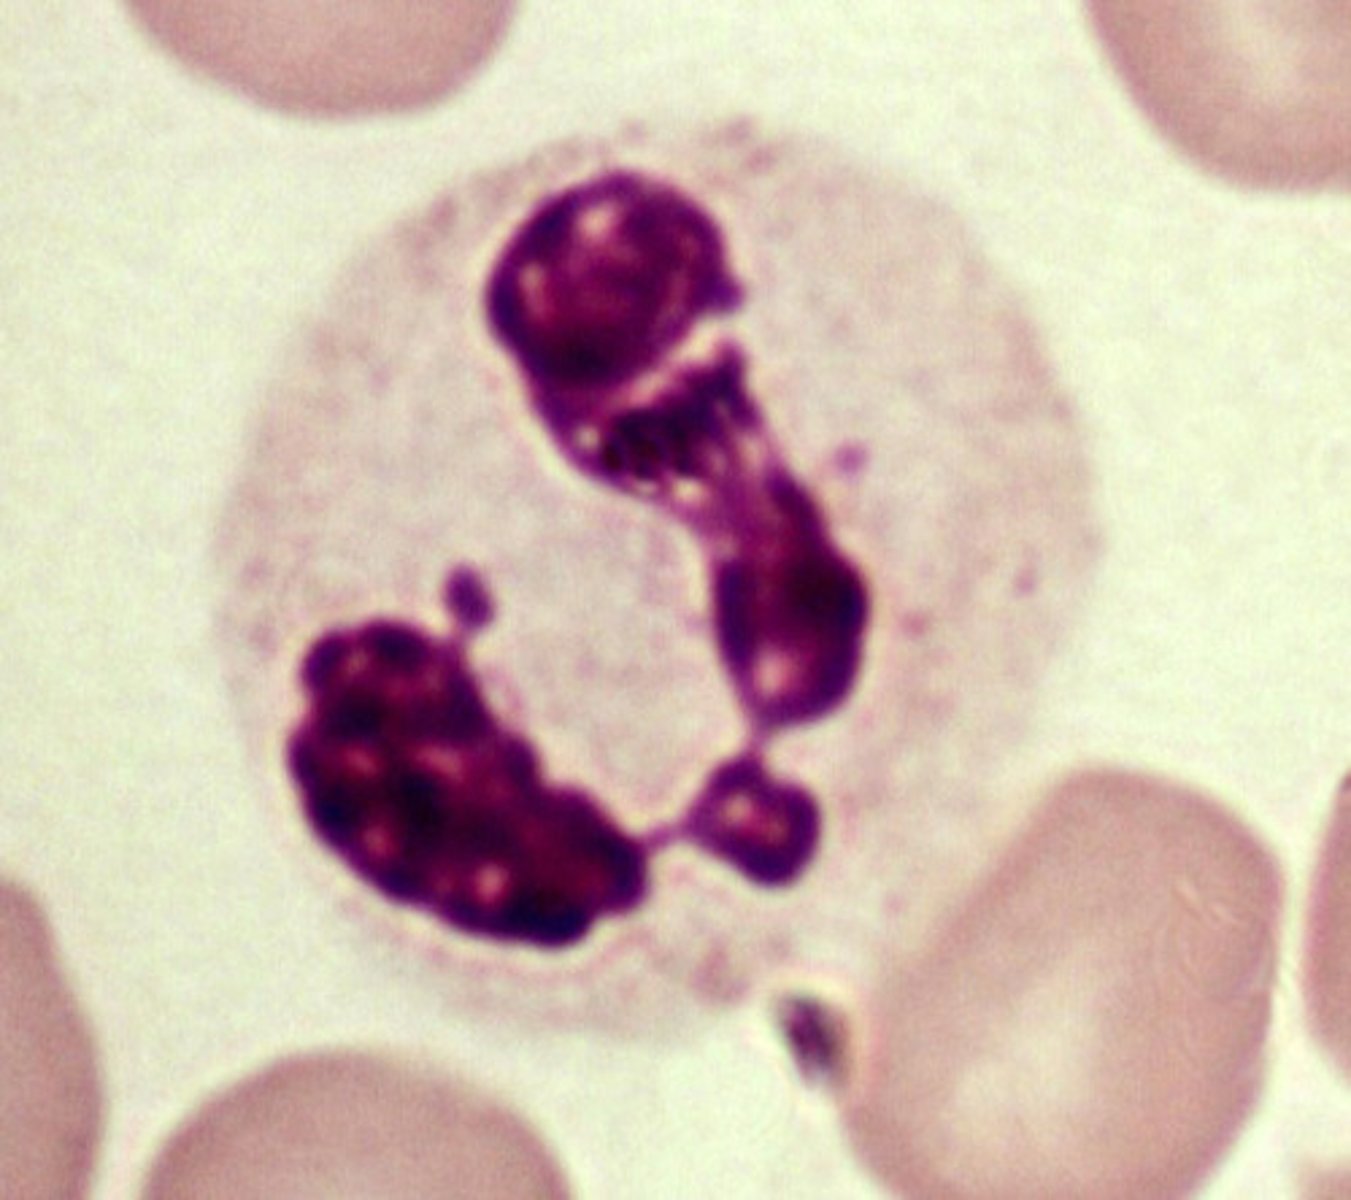
knowt flashcard image
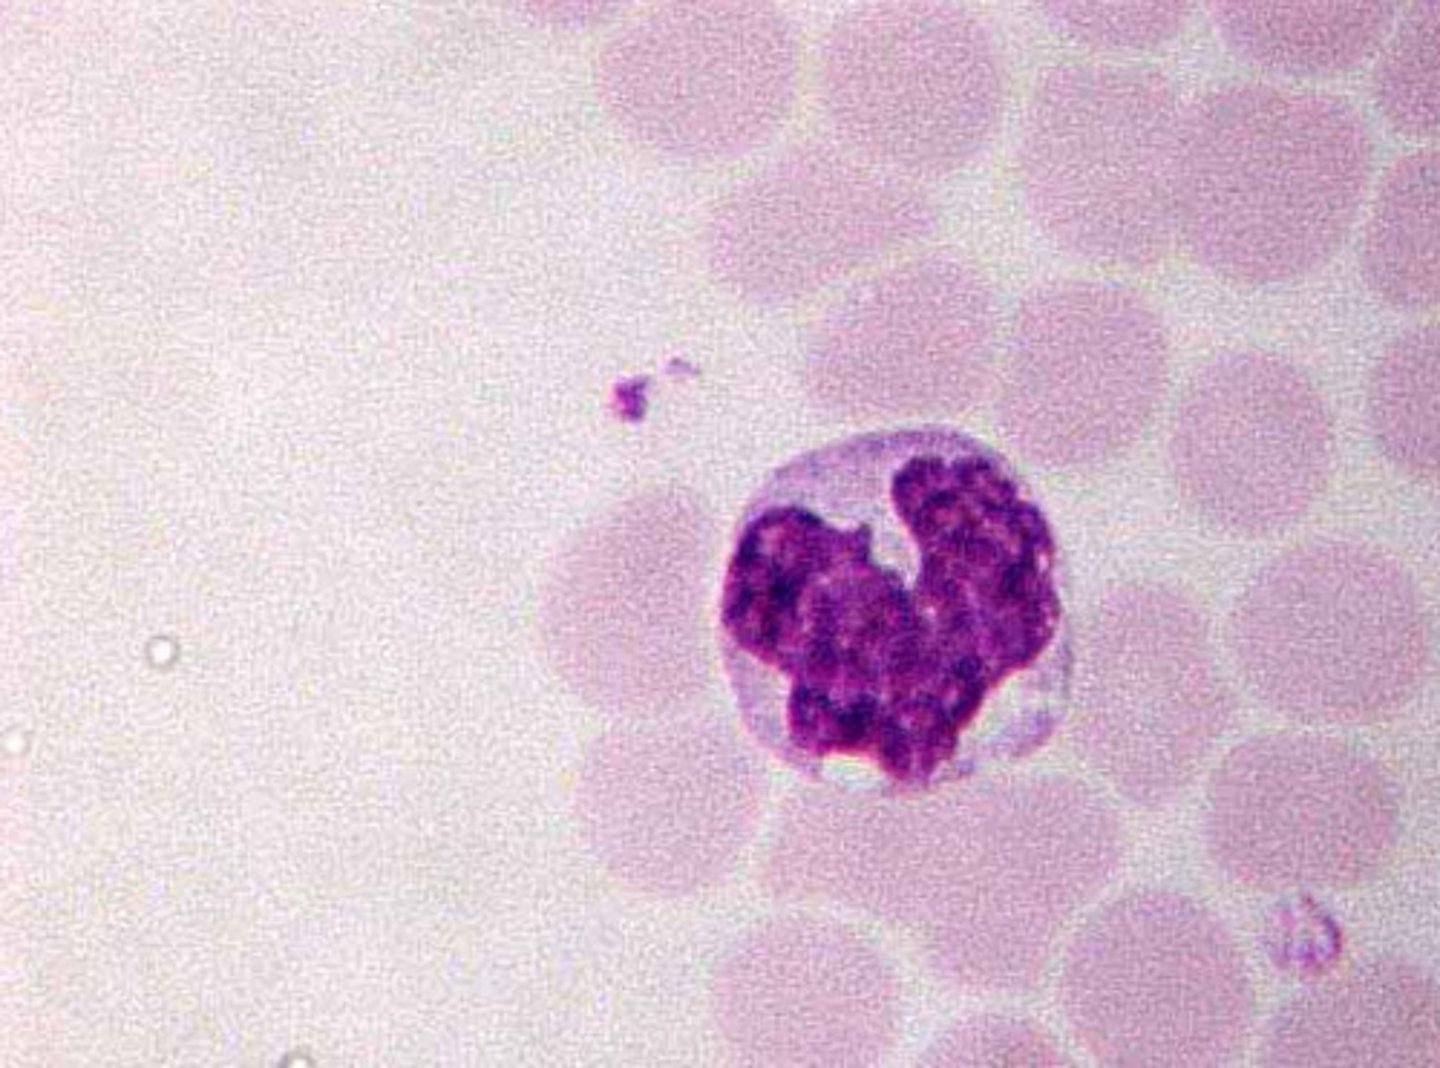
knowt flashcard image

1/86
Looks like no tags are added yet.
Name | Mastery | Learn | Test | Matching | Spaced | Call with Kai |
|---|
No analytics yet
Send a link to your students to track their progress
neutrophil

Neutrophil (granulocyte)
granulocyte, polylobed (3-5) nucleus; most common (60-70%)

Neutrophil (granulocyte)
granulocyte, polylobed (3-5) nucleus; most common (60-70%)

neutrophil

Neutrophils 60- 70%
purple. segmented nuclei .

Eosinophils (granulocyte)
dark red; bilobed (2 lobes) nucleus; 2-4%

lymphocyte

Eosinophils (granulocyte)
dark red; bilobed (2 lobes) nucleus; 2-4%

Basophils (granulocyte)
stain dark blue/purple; bilobed/irregular nucleus; 0.5-1%

Monocytes (no granules--> very few)
stain lavender; looks fuzzy because of lack of granules; very large; kidney bean/horse-shoe nucleus; 3-8%

Lymphocytes 25-30%
purple- little cell, large nuclei.

basophil

eosinophil

Basophils (granulocyte)
stain dark blue/purple; bilobed/irregular nucleus; 0.5-1%

Lymphocytes (very little cytoplasm, so little granules)
large, round nucleus makes up bulk of cell; little cytoplasm; 25-30%; smooth; stains purple

neutrophil

Monocyte 3-8%
purple - kidney shaped nuclei. Mega sized cell

lymphocyte

Monocytes (no granules--> very few)
stain lavender; looks fuzzy because of lack of granules; very large; kidney bean/horse-shoe nucleus; 3-8%

monocyte

Eosinophil 2-4%
red. two lobed nuclei.

eosinophil

Lymphocytes (very little cytoplasm, so little granules)
large, round nucleus makes up bulk of cell; little cytoplasm; 25-30%; smooth; stains purple

basophil

Basophil 0.5-1%
purple. dark granules (dots)

lymphocyte

Erythrocytes
Red Blood Cells

monocyte

Thrombocytes
platelets. helps in wound healing

eosinophil

Leukocytes
white blood cells

fights parasites
eosinophils
basophil

lymphocyte

releases histamine
basophils
monocyte
become macrophages. cleans debris by phagocytosis
monocyte
neutrophil

gains resistance as they fight foreign invaders. are low in individuals with HIV/AIDs
lymphocyte
neutrophil

most common of the WBCs
neutrophil
neutrophil

Granulocytes
contains granules when stained
neutrophil
Agranulocytes
does not contain granules when stained
neutrophil

Lymphocyte and monocyte
agranulocyte
lymphocyte

Neutrophils, Eosinophils, basophil
granulocyte
monocyte

monocyte

basophil

lymphocyte

basophil

eosinophil
monocyte

lymphocyte

lymphocyte

lymphocyte

lymphocyte

neutrophil

lymphocyte

monocyte

eosinophil

basophil

basophil

basophil

lymphocyte

neutrophil
eosinophil

basophil

monocyte

neutrophil

lymphocyte

eosinophil

basophil

monocyte
monocyte

basophil

basophil

eosinophil

eosinophil

neutrophil

neutrophil

monocyte

monocyte

monocyte
